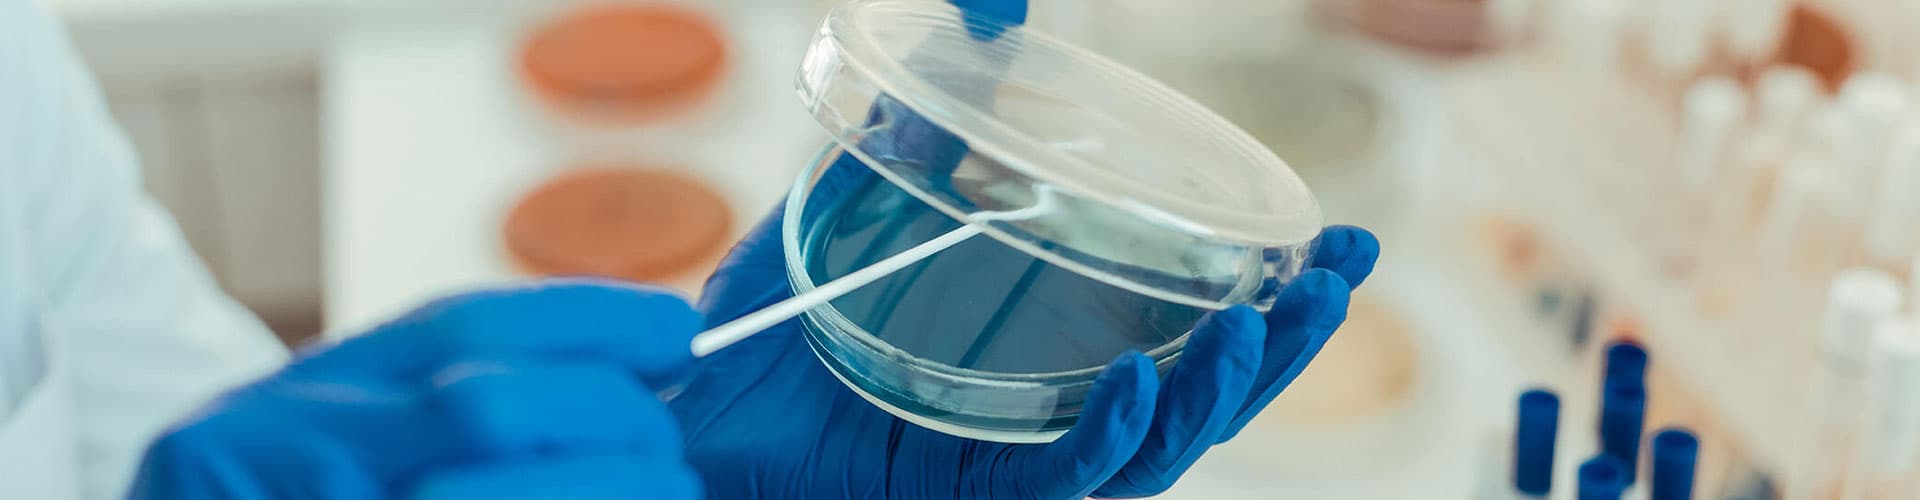
Product

About Lenvatinib Mesylate (Form-C) API
Therapeutic Category抗癌/抗肿瘤
CAS Number
API Technology
High Potent
Dose Form
Oral Solid/Capsules
Dr Reddy's Development Status
Available
Available Regulatory Filing
USDMF, Brazil DMF, Canada DMF, Korea DMF
Dr. Reddy's的专长
Dr. Reddy's总部位于印度海得拉巴,是全球领先的活性药物成分(API)供应商之一。 Dr. Reddy's的API业务是美国、欧洲、巴西、拉丁美洲、日本、中国、韩国和新兴市场的制药公司的首选合作伙伴。
Dr. Reddy's博士的API业务在过去30多年来在开发和制造复杂API(如类固醇,多肽,复杂长链分子和高效API(HPAPI /肿瘤药物))方面所建立的深厚技术优势中茁壮成长。 我们在知识产权和法规事务方面的实力可以帮助我们始终如一地达到并超越监管标准,从而为这一专业知识提供补充。 Dr. Reddy's博士 甲磺酸仑伐替尼(晶型 C及) API是研发,知识产权和监管方面广泛专业知识的结果。
帮助我们的客户率先进入市场的关键组成部分是响应式供应链。 我们通过确保所有设施都高效运行并达到最新的质量,安全和生产率标准来实现这一目标。 业务和工厂之间的强大互联可以快速响应动态的市场变化,从而避免短缺并满足需求的突然激增。
Related APIs
Request for Quotation
Get in touch with us by filling out the form below. Our team will reach out to you shortly!
免责声明
本網站上的任何信息,包括對任何產品或服務的任何提及,均不構成銷售要約或被解釋為代表銷售要約。受有效專利保護的產品不得提供或供應用於商業用途。但是,在某些情況下,雷迪博士可自行決定並根據當地法律要求,在存在此類監管豁免的任何地方,提供此類產品的研究數量,以根據《印度專利法》第 107A 條(Bolar 豁免)進行監管提交。購買者應對其各自市場的產品或服務(包括專利情況)進行獨立評估,並對所有與專利相關的責任負責。 Dr. Reddy's 不承擔任何明示或暗示的保證,包括但不限於適銷性、適用於特定用途和非侵權的保證。